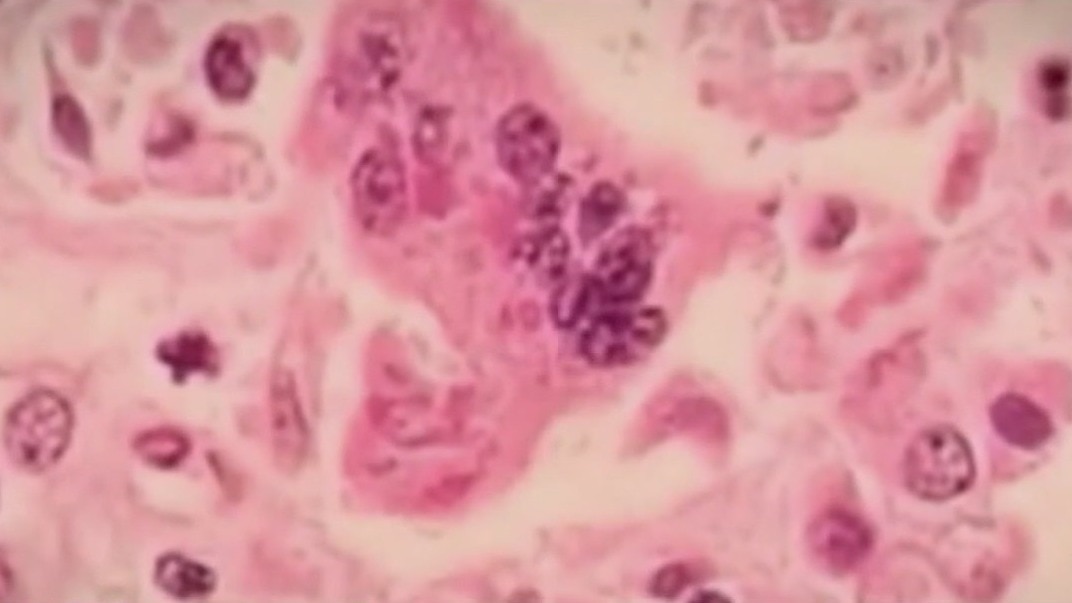

Maricopa County warns of possible measles exposure
Maricopa County Public Health says an international visitor tested positive for measles and may have exposed people to the infection on Saturday, Jan. 27. Two locations of exposure have been identified -- the Garden Grille and Bar inside the Hilton Garden Inn in downtown Chandler, and Twin Peaks Camelback in Phoenix. Symptoms of measles include fever, cough, runny nose, watery eyes and a rash.
Latest Videos
Maricopa County warns of possible measles exposure

FOX 10 Salutes: Alex Hernandez

Iran war: Trump hints peace talks could resume soon

'Super' El Niño l Weather Wisdom Wednesday

1 killed in Wittmann semi-truck crash on U.S. 60

DNA links Arizona woman to newborn's 1981 murder

Iran war: Negotiations to resume as U.S. and Iran look for compromise

Proposed Old Town parking garage moves forward despite resident pushback

Pilot says 'aviation gods were with us' during emergency plane landing

Man gets life in prison with possibility of parole for mother's murder

Brothers pursue identical engineering degrees at ASU

APS employees save toddler running near street in Phoenix

School for special needs students abruptly closes

Pilot recalls crash landing on 7th street in Phoenix

New details surface in Dusten Mullen investigation

Michelin: Famed food guide coming to Arizona

Businesses adding 'gas surcharges' onto customers

Arizona Snowbowl reopens after getting snow

AZ man to serve life in prison for deadly shooting

Man fighting valley fever at Mayo Clinic

Impact of gas, shipping costs, AI in real estate, Phoenix Suns preview | FOX 10 Talks

Barricade ends in deadly shooting; latest Iran developments

Eric Swalwell: Ruben Gallego speaks out

DHS funding debate heating up on Capitol Hill

Gov. Hobbs announces bill signing moratorium


